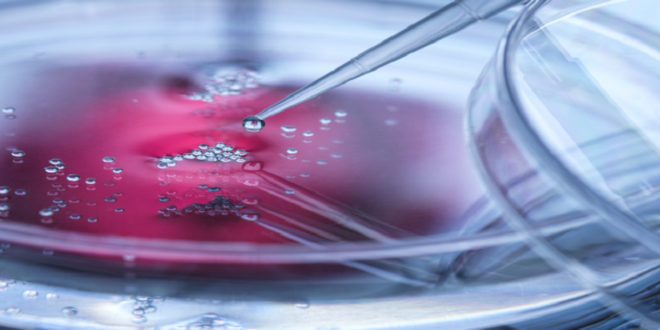

منبر العراق الحر :
أظهرت دراسة جديدة، أجرتها جامعة جنوب كاليفورنيا (ليونارد ديفيس)، نموذجا مبتكرا للإجهاد الميكانيكي يوضح كيف يمكن أن تؤثر صلابة الأنسجة والبيئة المحيطة على الصحة والعمر.
يعرف الإجهاد الميكانيكي بأنه نوع من الضغوط التي تتعرض لها الخلايا أو الأنسجة بسبب تأثيرات خارجية، مثل الشد أو الضغط أو الالتواء أو الانحناء. ويتضمن ذلك أي نوع من القوة الميكانيكية التي تؤثر على بنية الأنسجة، ما يؤدي إلى تغييرات في شكلها أو وظيفتها.
وبهذا الصدد، قال الأستاذ المساعد ريو سانابريا، المعد الرئيسي للدراسة: “تعد دراسة الإجهاد الميكانيكي مهمة لأن العديد من الأنسجة تصبح أكثر صلابة مع تقدم العمر، وترتبط هذه الصلابة بعدد من الأمراض المرتبطة بالشيخوخة، مثل السرطان”.
وأضاف سانابريا: “تُحدّد الأورام عادة من خلال الشعور بكتلة صلبة، حيث تتميز الأورام الصلبة بزيادة ملحوظة في الصلابة مقارنة بالأنسجة السليمة. ويمكن أن يؤثر نمو الخلايا في البيئات الأكثر صلابة بشكل كبير على صحة الكائن الحي ووظائفه”.
وفي الدراسة، سعى الباحثون إلى إيجاد طريقة بسيطة لتطبيق الضغط الميكانيكي على كائن نموذجي لدودة خيطية مجهرية من نوع C. elegans. وتم زراعة الحيوانات على سطح صلب، وقاموا بمقارنة صحتها بالحيوانات التي نمت في ظروف طبيعية.
وأظهرت النتائج أن الحيوانات التي نمت على الركيزة الأكثر صلابة كانت لديها مقاييس صحة أقل، بما في ذلك انخفاض في التكاثر ووظيفة العضلات. ومع ذلك، لوحظ أن هذه الحيوانات عاشت لفترة أطول.
وقد يكون هذا الارتفاع المفاجئ في متوسط العمر ناتجا عن زيادة مقاومة الإجهاد وتغيرات في بعض المكونات الخلوية، مثل الميتوكوندريا (عضيات خلوية تُعرف بأنها “محطات الطاقة” في الخلايا).
وأشار الباحثون إلى أن التغيرات التي لوحظت لدى C. elegans المعرضة لركائز أكثر صلابة، مثل زيادة القدرة على تحمّل الإجهاد، تشبه التغيرات الموجودة في الخلايا السرطانية. وبالتالي، يمكن استخدام نماذج الإجهاد الميكانيكي لاختبار أدوية تثبيط نمو الخلايا السرطانية.
نشرت الدراسة في مجلة PLOS ONE.
المصدر: ميديكال إكسبريس
 منبر العراق الحر منبر العراق الحر
منبر العراق الحر منبر العراق الحر